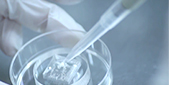

企业简介
企业简介
COMPANY PROFILE

 发展历程
发展历程
DEVELOPMENT HISTORY

组织架构
组织架构
ORGANIZATIONAL STRUCTURE

 企业优势
企业优势
ENTERPRISE ADVANTAGES
 企业核心价值观
企业核心价值观
CORE VALUES OF THE ENTERPRISE
坚持创新
不断提升技术进步和产品革新,引入新技术和新理念,推动行业的前沿发展和科学进步。
追求卓越
质量至上,确保每一项产品和服务都达到最高质量标准,以客户需求为中心,提供优质解决方案和服务。
科技驱动
利用前沿的科技提升产品性能和服务效果,引领行业发展,为社会的健康与美丽贡献我们的力量。
合作共赢
强调内部和外部的合作与共赢,与合作伙伴和客户建立互利共赢的关系。积极履行社会责任,关注社会公益。

 企业宗旨
企业宗旨
CORPORATE PURPOSE

 企业发展使命
企业发展使命
ENTERPRISE DEVELOPMENT MISSION
我们的企业发展使命是“让前沿医疗科技服务所有人”。我们致力于将先进的医疗科技应用于实际,以提高医疗服务的普及性和可及性。通过持续的技术创新和产品研发,我们希望能让更多的人享受到高质量的医疗服务,提高生活质量和健康水平。
 企业发展愿景
企业发展愿景
ENTERPRISE DEVELOPMENT VISION
我们的企业发展愿景是“成为生物材料及医疗器械行业前行者”,以市场适应力强、科技含量性价比优越的产品来满足客户的需求。通过创新的研发、精益求精的生产工艺以及优质的客户服务,推动医疗器械行业的发展,为用户提供先进、可靠的医疗解决方案。我们的目标是用科技的力量,提升医疗水平,让每一个客户都能享受到卓越的产品体验和服务。